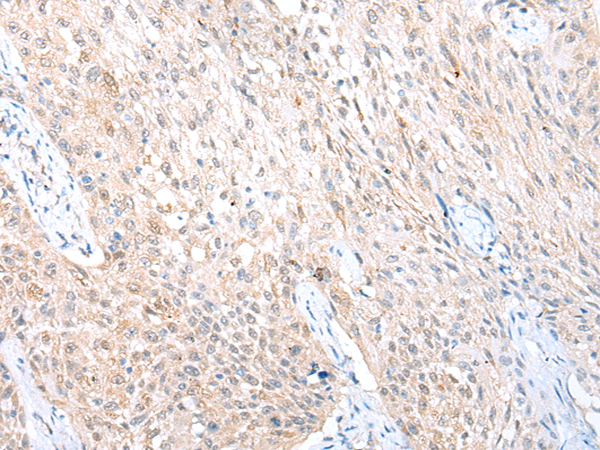

中文名稱:兔抗ADIPOR1多克隆抗體
|
Background: |
This gene encodes a protein which acts as a receptor for adiponectin, a hormone secreted by adipocytes which regulates fatty acid catabolism and glucose levels. Binding of adiponectin to the encoded protein results in activation of an AMP-activated kinase signaling pathway which affects levels of fatty acid oxidation and insulin sensitivity. A pseudogene of this gene is located on chromosome 14. Multiple alternatively spliced transcript variants have been found for this gene. |
|
Applications: |
ELISA, IHC |
|
Name of antibody: |
ADIPOR1 |
|
Immunogen: |
Synthetic peptide of human ADIPOR1 |
|
Full name: |
adiponectin receptor 1 |
|
Synonyms: |
CGI45; PAQR1; ACDCR1; CGI-45; TESBP1A |
|
SwissProt: |
Q96A54 |
|
ELISA Recommended dilution: |
2000-5000 |
|
IHC positive control: |
Human liver cancer and human lung cancer |
|
IHC Recommend dilution: |
20-100 |

購物車
購物車 幫助
幫助
 021-54845833/15800441009
021-54845833/15800441009
